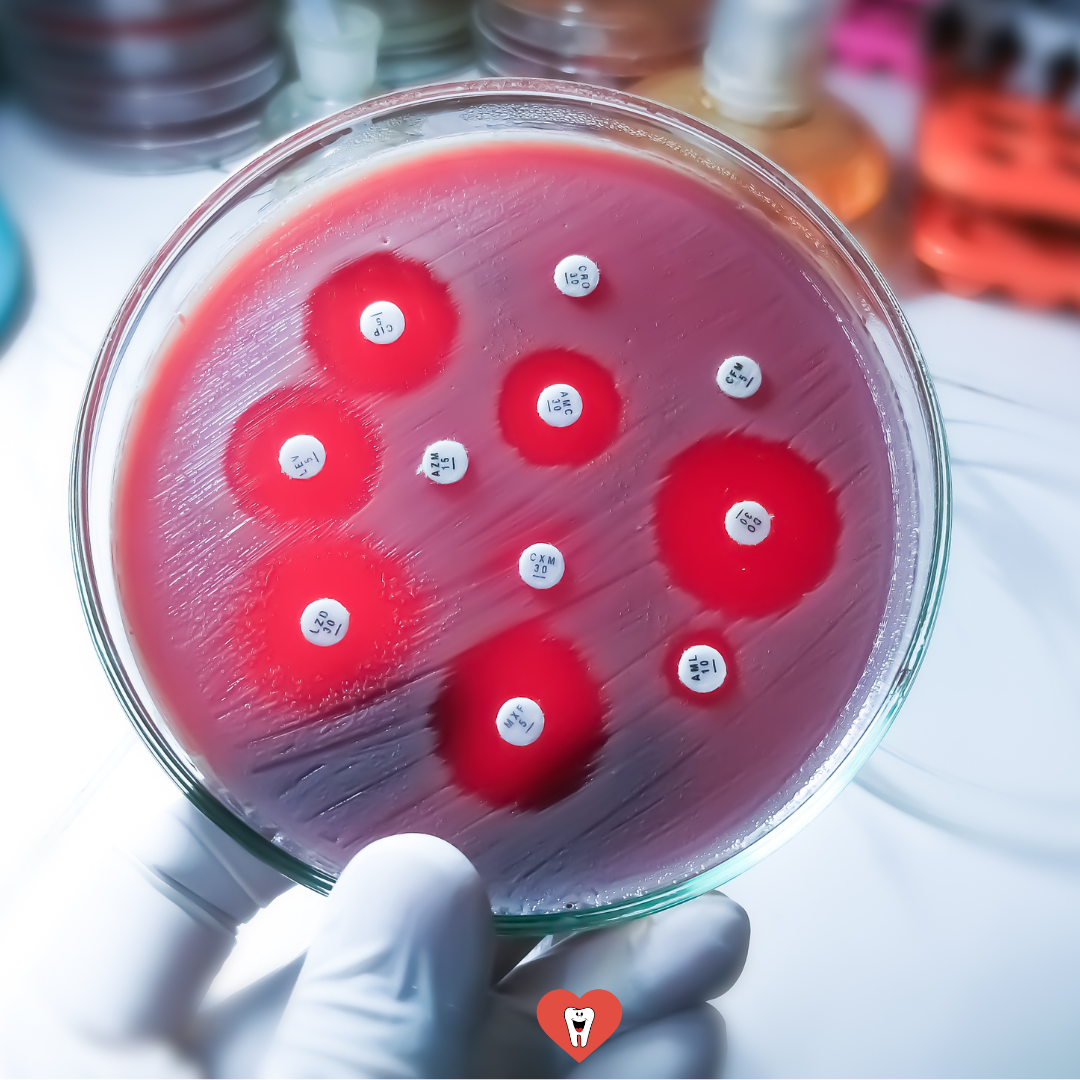

Bem-vindo
-

Anestesia Que ‘Não Pega’ na Hora do Canal?
Você já passou pela frustração de aplicar corretamente a anestesia e, mesmo assim, o paciente continuar sentindo dor? Se sim, saiba que você não está sozinho – e, mais importante ainda: o problema provavelmente não está em você. O Desabafo de Muitos Dentistas “Fiz o bloqueio certo, revisei toda a técnica, troquei o anestésico, infiltrei…
-

“Nem Fui Ao Dentista, Resolvi a Dor em Casa”
“Imagina pagar consulta para dentista dar receita…” Lembro até hoje, na graduação de Odontologia, quando toda a minha sala ficou desconcertada ao ouvir de um professor – conhecido por sua rigidez e aspereza – que iríamos nos formar e não seríamos nada. Ele dizia que só depois de uns 5 anos de formados é que…
-
A resistência aos antibióticos cresceu 40%. O dentista tem papel nisso?
Entre 2018 e 2023, a resistência a antibióticos aumentou em mais de 40% das combinações monitoradas entre microrganismos e medicamentos, segundo o mais recente relatório da Organização Mundial da Saúde (OMS). Em outras palavras: quase metade dos principais pares “bactéria + antibiótico” do planeta estão se tornando ineficazes.Isso significa que, a cada ano, cresce o…
-

Dor Intensa Durante a Irrigação dos Canais: O Que Fazer?
Saiba como reconhecer e agir diante do extravasamento de hipoclorito de sódio durante a irrigação — e evite consequências graves para o seu paciente. Quando a Dor Vence a Anestesia Você está no meio de um tratamento endodôntico, o isolamento absoluto está impecável, o paciente anestesiado — e, de repente, ele sente uma dor aguda,…
-

Dor com Curativo Intracanal: O que houve de errado?
Entenda as principais causas da dor intensa após a medicação intracanal, aprenda a identificar sinais críticos e descubra estratégias eficazes para resolver e prevenir complicações endodônticas. Introdução: Quando a Dor Surpreende Mesmo Após o Tratamento Você já enfrentou um paciente que, mesmo após a aplicação da medicação intracanal, retornou ao consultório relatando dor intensa e…
-

Cárie Profunda: Como Saber Se Vai Dar Canal?
Seu paciente está sentado na cadeira na sua frente e você olha para a radiografia com aquela cárie muito próxima do canal.E aí, deu canal? Tomar a decisão correta é fundamental para evitar falhas, preservar a vitalidade pulpar sempre que possível e garantir segurança para o paciente. A seguir, compartilhamos um passo a passo decisivo…
-

Dois Colegas Não Quiseram Mexer Nesse Abscesso…
E Foi Isso Que Aconteceu. Introdução: A Gravidade do Abscesso Endodôntico Em muitos atendimentos odontológicos de urgência, é comum o profissional adotar uma conduta passiva diante de abscessos de origem endodôntica. Prescreve-se apenas antibiótico e analgésico, postergando a intervenção local. Essa prática, além de inadequada, pode colocar o paciente em risco grave. A seguir, relato…
-

Como Saber Se a Dor Ao Frio Já É Canal?
Saiba identificar os sinais clínicos da pulpite irreversível e quando indicar o tratamento endodôntico. Veja as cinco principais características e como realizar um diagnóstico preciso. Dor ao Gelado — O Que Esse Sintoma Pode Indicar? Quando o paciente chega ao consultório relatando dor ao contato com o gelado, é sinal de que a polpa dentária…
-

Dor Durante a Obturação do Canal: Como Proceder?
Você está terminando o preparo endodôntico, iniciando a obturação dos canais, e, de repente, o paciente começa a relatar dor. Essa situação, além de desconfortável para o paciente, pode gerar insegurança para o profissional. Mas afinal, por que isso acontece? E, principalmente, o que fazer nesses casos? O Motivo Mais Comum: Fim do Efeito da…
-

Dor após endodontia: Quando devemos investigar mais a fundo?
Poucas coisas mexem tanto com a gente quanto ouvir de um paciente, dias depois de uma endodontia bem conduzida: “Doutor, ainda estou com dor.” Aquela sensação de que algo escapou. De que, mesmo tendo seguido o protocolo, algo não saiu como o planejado.E, no fundo, a pergunta que vem é sempre a mesma: “Será que…
Recomendação de livros?